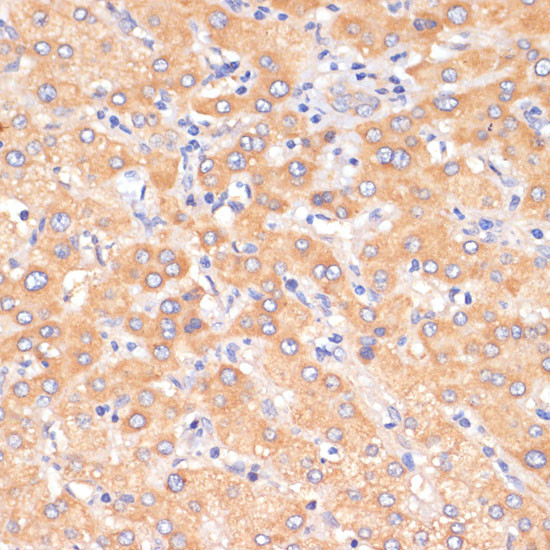
PDCD2L Antibody in Immunohistochemistry (Paraffin) (IHC (P))

Search
Invitrogen
PDCD2L Polyclonal Antibody
{{$productOrderCtrl.translations['antibody.pdp.commerceCard.promotion.promotions']}}
{{$productOrderCtrl.translations['antibody.pdp.commerceCard.promotion.viewpromo']}}
{{$productOrderCtrl.translations['antibody.pdp.commerceCard.promotion.promocode']}}: {{promo.promoCode}} {{promo.promoTitle}} {{promo.promoDescription}}. {{$productOrderCtrl.translations['antibody.pdp.commerceCard.promotion.learnmore']}}
图: 1 / 3
PDCD2L Antibody (PA5-96664) in IHC (P)



Please note: We are reviewing Western blot images included in the antibody testing data in our catalog, including those provided by third parties. Unless expressly labeled or annotated as “raw-unedited”, Western blot images included in the antibody testing data in our catalog may have been edited, optimized or otherwise adjusted for presentation.
产品信息
PA5-96664
种属反应
宿主/亚型
分类
类型
抗原
偶联物
形式
浓度
规格
纯化类型
保存液
内含物
保存条件
运输条件
RRID
产品详细信息
Immunogen sequence: MAAVLKPVLL GLRDAPVHGS PTGPGAWTAS KLGGIPDALP TVAAPRPVCQ RCGQPLALVV QVYCPLEGSP FHRLLHVFAC ACPGCSTGGA RSWKVFRSQC LQVPEREAQD AQKQGNSLAA EDWCEGADDW GSDTEEGPSP QFTLDFGNDA SSAKDVDWTA RLQDLRLQDA VLGAAHPVPP GLPLFLPYYI CVADEDDYRD FVNLDHAHSL LRDYQQREGI AMDQLLSQSL PNDGDEKYEK TIIKSGDQTF YKFMKRIAAC QEQILRYSWS GEPLFLTCPT SEVTELPACS QCGGQRIFEF QLMPALVSML KSANLGLSVE FGTILVYTCE KSCWPPNHQT PMEEFCIIQE DPDELLFK; Positive Samples: HeLa, MCF7, SKOV3, BT-474, Mouse testis, Mouse brain, Mouse heart
靶标信息
Over expression of PDCD2L attenutates TNF-alpha release in Daudi cells. PDCD2L over-expression restrained proliferation of HEK293T cells. DNA/flow cytometry analysis showed that the over-expression of PDCD2L severely delays cell cycle progression at S phase. These all suggest that PDCD2L might play a role in apoptosis.
仅用于科研。不用于诊断过程。未经明确授权不得转售。
篇参考文献 (0)
生物信息学
蛋白别名: MGC13096; Programmed cell death protein 2-like; uS5 assembly chaperone PDCD2L
基因别名: 6030457N17Rik; Pdcd2l; RGD1308249
UniProt ID: (Mouse) Q8C5N5
Entrez Gene ID: (Rat) 689637, (Mouse) 68079